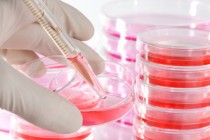

23-10-2013
|
16.48
|
Provinciales
Se suicidó en un psiquiátrico: ordenan indemnizar a la familia
Los jueces de la Cámara de Apelación en lo Civil y Comercial de La Matanza advirtieron que en la historia clínica la médica psiquiatra que lo asistía dejó asentado que el muchacho le dijo que se iba a...